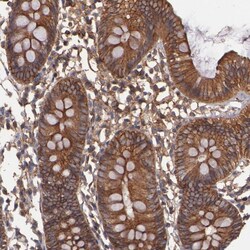
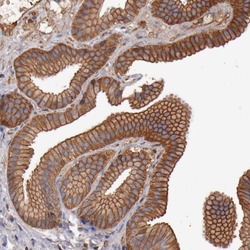

Antibody data
- Antibody Data
- Antigen structure
- References [1]
- Comments [0]
- Validations
- Immunocytochemistry [2]
- Immunohistochemistry [4]
Submit
Validation data
Reference
Comment
Report error
- Product number
- PA5-51645 - Provider product page

- Provider
- Invitrogen Antibodies
- Product name
- TMOD3 Polyclonal Antibody
- Antibody type
- Polyclonal
- Antigen
- Recombinant protein fragment
- Description
- Immunogen sequence: LEKEALEHKD REDYVPYTGE KKGKIFIPKQ KPVQTFTEEK VSLDPELEEA LTSASDTELC DLAAILGMHN LITNTKFCNI MGSSNGVDQE HFSNVVKGEK ILPVFDEPPN PTNVEESLKR TKENDAHLVE VNLNNIKNIP IPTLKD Highest antigen sequence identity to the following orthologs: Mouse - 88%, Rat - 90%.
- Reactivity
- Human, Mouse, Rat
- Host
- Rabbit
- Isotype
- IgG
- Vial size
- 100 μL
- Concentration
- 0.10 mg/mL
- Storage
- Store at 4°C short term. For long term storage, store at -20°C, avoiding freeze/thaw cycles.
Submitted references Differential Alternative Polyadenylation Landscapes Mediate Hematopoietic Stem Cell Activation and Regulate Glutamine Metabolism.
Sommerkamp P, Altamura S, Renders S, Narr A, Ladel L, Zeisberger P, Eiben PL, Fawaz M, Rieger MA, Cabezas-Wallscheid N, Trumpp A
Cell stem cell 2020 May 7;26(5):722-738.e7
Cell stem cell 2020 May 7;26(5):722-738.e7
No comments: Submit comment
Supportive validation
- Submitted by
- Invitrogen Antibodies (provider)
- Main image

- Experimental details
- Immunofluorescent staining of TMOD3 in human cell line U-2 OS shows positivity in cytoplasm & actin filaments. Samples were probed using a TMOD3 Polyclonal Antibody (Product # PA5-51645).
- Submitted by
- Invitrogen Antibodies (provider)
- Main image

- Experimental details
- Immunofluorecent analysis of TMOD3 in human cell line U-2 OS using TMOD3 Polyclonal Antibody (Product # PA5-51645). Staining shows localization to cytosol and actin filaments.
Supportive validation
- Submitted by
- Invitrogen Antibodies (provider)
- Main image
- Experimental details
- Immunohistochemical analysis of TMOD3 in human colon using TMOD3 Polyclonal Antibody (Product # PA5-51645) shows strong cytoplasmic positivity in glandular cells.
- Submitted by
- Invitrogen Antibodies (provider)
- Main image

- Experimental details
- Immunohistochemical analysis of TMOD3 in human lymph node using TMOD3 Polyclonal Antibody (Product # PA5-51645) shows strong cytoplasmic positivity in non-germinal center cells.
- Submitted by
- Invitrogen Antibodies (provider)
- Main image
- Experimental details
- Immunohistochemical staining of TMOD3 in human gallbladder using a TMOD3 Polyclonal Antibody (Product # PA5-51645) shows strong cytoplasmic positivity in glandular cells.
- Submitted by
- Invitrogen Antibodies (provider)
- Main image

- Experimental details
- Immunohistochemical analysis of TMOD3 in human cerebral cortex using TMOD3 Polyclonal Antibody (Product # PA5-51645) shows strong cytoplasmic positivity in neurons.